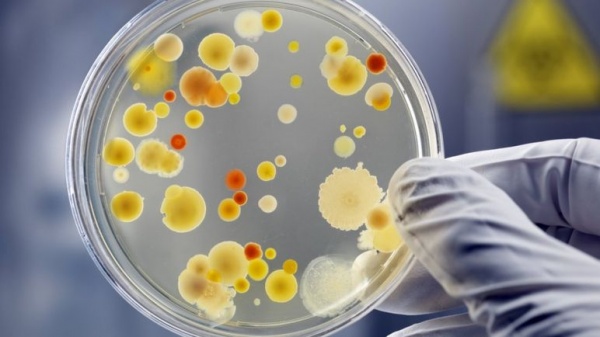
Bağırsak bakterileri kanser tedavisini 'güçlendiriyor'

Biyoteknoloji / Sağlık
Sağlık alanındaki biyoteknolojik çalışmalar;
- Gen terapisi, rekombinant aşılar, biyofarmasötikler,
- İnsanın zarar görmüş veya işlevini kaybetmiş organ ve dokularının değiştirilmesi için yapay organ ve doku üretim konularını kapsar.